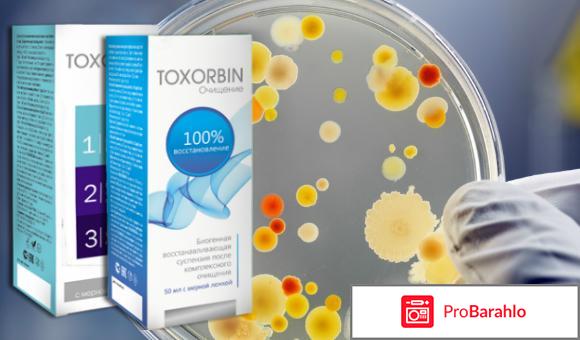
Toxorbin отрицательные отзывы

Toxorbin
Отзыв про Toxorbin
В наше время большинство людей стали применять только те препараты, которые произведена на натуральном составе. Оно то и понятно почему, ведь в нашей жизни все только химия и ничего натурального. А здесь же идет речь о здоровье человека, что в наше время очень дорогое удовольствие. И вот только когда мне исполнилось 30 лет я искренне начала понимать, сколько я ошибок наделала и как испортила себе здоровье простыми глупыми поступками.
У меня наибольшая проблема со здоровьем касается желудочно-кишечного тракта. Дело в том, что в школе еще я всегда отказывалась от еды. ну, во первых, мне жалко было тратить деньги родителей, поэтому я всегда говорила, что я просто не хочу есть и все деньги просто отлаживала, и когда приходил день, когда вообще не было, то мои, пусть и не большие сбережения, но помогали прожить и позволяли купить хлеба. Ну когда немного повзрослела, тогда стала вообще голодать, чтобы не поправиться, ведь там уже и первая любовь подоспела, возраст сложный. Ну а потом я стала студенткой. Я не умела вообще ничего готовить, все знала только на теории и за все на тот момент время я ни разу ничего не готовила. А вот стала я студенткой и училась далеко от родителей - в другом городе, где должна была сама себя кормить. И вот там уже все и всплыло: у меня просто катастрофические были проблемы с желудком, но я очень долго в этом не признавалсь и просто терпела, даже на лечение я жалела денег. В итоге, на первом курсе я узнала, что у меня уже хронический гастрит, ну а на третьем - что у меня язва желудка, что очень неприятно!

Но вот, когда родители все таки узнали, я ответила на это тем, что я сама натворила, и сама буду решать свои проблемы (хоть на тот момент я получала только небольшую стипендию и немного иногда подрабатывала). Мне в одной из больниц, когда я все таки решилась обратиться, порекомендовали препарат Toxorbin. Именно этот препарат поможет очистит организм от всего вредного.
Что это за препарат?
Toxorbin - это комплексный уникальный препарат, с помощью которого из организма выводятся шлаки, токсины, а ведь все это вредные вещества, которые и провоцируют разной степени заболевания. При чем средство выводит все вредные вещества не только из желудочно-кишечного тракта, но и из крови, тканей мозга, мышечных тканей, лимфы,
Я приобрела данное средство за 1250 рублей.

Какой же эффект от применения средства?
В результате применения средства производитель утверждает, что
- оздоравливающий эффект уже будет заметен на 5 день после начала применения препарата
- снимает воспалительные процессы
- улучшает работу мочеполовой системы
- снимает проявления герпеса и аллергии
- улучшает состав крови
- нормализация процесса пищеварения
Состав средства
- зооглея (выявляет источник интоксикации организма и выводит его)
- бурые морские водоросли ( уничтожают холестерин, активизируют и нормализируют кровообращение, выводит из организма токсины, нормализирует водный баланс и обменные процессы)
- шиитаке (борется с болезнями почек, улучшает кровообращение, снижает массу тела)
- корни одуванчика (обновляют клетки, транспортируют питательные вещества в организм)
- амаранта (тонизирует, нормализирует работу мочеполовой системы)
- семена овса (помогает процессу усвоения углеводов, укрепляет иммунитет)
- плоды бузины (доставляет полезные вещества в организм)
- семена шамбалы

препарат просто идеальное средство для того, чтобы хорошо очистить свой организм от вредных веществ, более того, еще и способствует укреплению иммунитета, активизирует обменные процессы, притупляет период старения.
препарат мне понравился, тем более, он снял болезненные симптомы язвенной болезни, чего раньше мне нечем не удавалось сделать.
Всем привет.Я очень часто читала да и слышала о том, что надо хотя бы раз в месяц но проводить очистку организма. Пока я была маленькой, то не знала вообще зачем это надо, но теперь я просто уверена в том, что эту процедуру надо делать и обязательно!!!
Все дело в том, что вот как не крути, а от того, какое состояние твое внутреннего мира ( желудочно-кишечного тракта) такая ситуация будет и у тебя на лице. Я никогда в это не верила, а вот теперь очень многое стала понимать)))А поэтому я решила, что мне просто необходимо проводить такую очистку организма, потому что у меня очень активный образ жизни, но питаюсь очень неправильно, а поэтому только могу представить что там у меня происходит((((((
очень много всего по поводу очищения организма я прочитала в интернете и увидела один отзыв, который меня больше всего заинтересовал. Писала этот отзыв девушка, которая как и положено делает очищение организма, только вот у меня были совсем другие понятия как это вообще надо делать, а в этом отзыве я прочитала и узнала, что все таки эта процедура может быть намного проще, чем кажется на первый взгляд.
В отзыве рекомендовалось при очистке от

Вот начала очищать свой организм, и просто нарадоваться не могу!!! Работает препарат очень мягко, и в то же время, очень хорошо очищает организм от всех вредных токсинов, которые, кстати, могут спровоцировать очень сложные заболевания. Я сразу признаюсь, что я ем многова-то сладкого, а тем более, если еще ваш организм употребляет алкоголь, никотин, жирное, то вам просто необходимо очищать свой организм. Ну вредных привычек у меня не, ну а сладкое у меня есть в рационе, но в меру. Так что вот такая вот у меня ситуация получается.
Сейчас есть очень большое разнообразие препаратовв, которые помогут вам очистить ваш организм, но мне больше всего понравился именно тот выбор, который посоветовала девушка в отзыве (спасибо нй за это большое!!). Все таки отзывы это просто отличная штука!!Реальные отзывы реально помогают!!!
Препарат Toxorbin действует мягко, но в то же время хорошо выводит всю гадость из вашего организма: шлаки, токсины, он еще и чистит сосуды, что в результате способствует улучшению кровообращения. И дальше по цепочке, ведь все это его действие положительно влияет на почки, печень, желчный пузирь. Да и вообще, что здесь много говорить, этот препарат чистит весь ваш организм!
Способ применения:
Принимать препарат "Toxorbin" надо по чайной ложке в день. Этот не из тех препаратов, который просто ужасный на вкус, я так не скажу. На вкус "Toxorbin" слегка сладковатый и все. Тоесть, принимать его можно и оно не противно))))

Состав препарата это просто идеальное сочетание только натуральный компонентов.
В инструкции к препарату указано, что принимать его можно не больше десяти дней, но этого времени вполне достаточно, чтобы потом просто приятно удивиться тому, насколько легко и просто. После этого ваш организм полностью будет оновленный)))
Условия хранения препарата в том, что его нельзя только хранить под прямыми солнечными лучами.
Препарат "Toxorbin", в основном, есть во всех аптеках, но признась честно, мне пришлось походить чтобы найти эти все аптеки. Во многих просто его не было. Цена этого препарата не столь и велика. Я заплатила за "Toxorbin" всего 990 рублей. На Украине его в аптеке видела за 400 гривен.
очень довольна тем, что вот выбрала из всех, которые есть препаратф для очищения организма именно Toxorbin. Стоит недорого, состав только натуральный, а вот работает на все 100!!! Так что теперь органим скажет только спасибо!!)))
-
Альтернативная медицинаАльтернативная медицина(2585)
-
Как правильно бегатьКак правильно бегать(1)
-
Косметика декоративнаяКосметика декоративная(2380)
-
Косметика ухаживающаяКосметика ухаживающая(6367)
-
Косметические принадлежностиКосметические принадлежности(592)
-
Косметические процедурыКосметические процедуры(1175)
-
Лекарственные средстваЛекарственные средства(11115)
-
Методы лечения и операцииМетоды лечения и операции(1177)
-
Очки и контактные линзыОчки и контактные линзы(154)
-
Парфюмерия и дезодорантыПарфюмерия и дезодоранты(1707)
-
Разное (красота и здоровье)Разное (красота и здоровье)(14105)
-
Средства гигиеныСредства гигиены(966)
-
Средства для похуденияСредства для похудения(3470)
-
Средства контрацепцииСредства контрацепции(259)
-
Средства увеличения грудиСредства увеличения груди(29)
-
Стрижки и прически для волосСтрижки и прически для волос(215)
